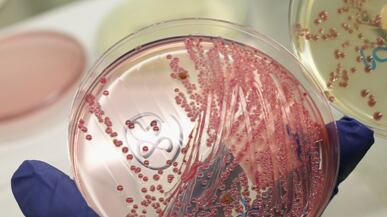
cheats/2011/06/02/e-coli-strain-has-rare-glue/e-coli-strain-unseen-before_lcco7u

Scientists studying the deadly E. coli strain that has struck Europe say it contains a rare “glue” that helps it bind to people’s intestines. That, combined with especially poisonous bacteria, may make it the most deadly strain to ever hit humans. So far 17 people have been killed in Europe, and 1,500 more have been sickened. After it sticks to the intestinal walls, the E. coli pumps out toxins, and can attack the kidneys and cause coma, seizure, and stroke.
Read it at Reuters